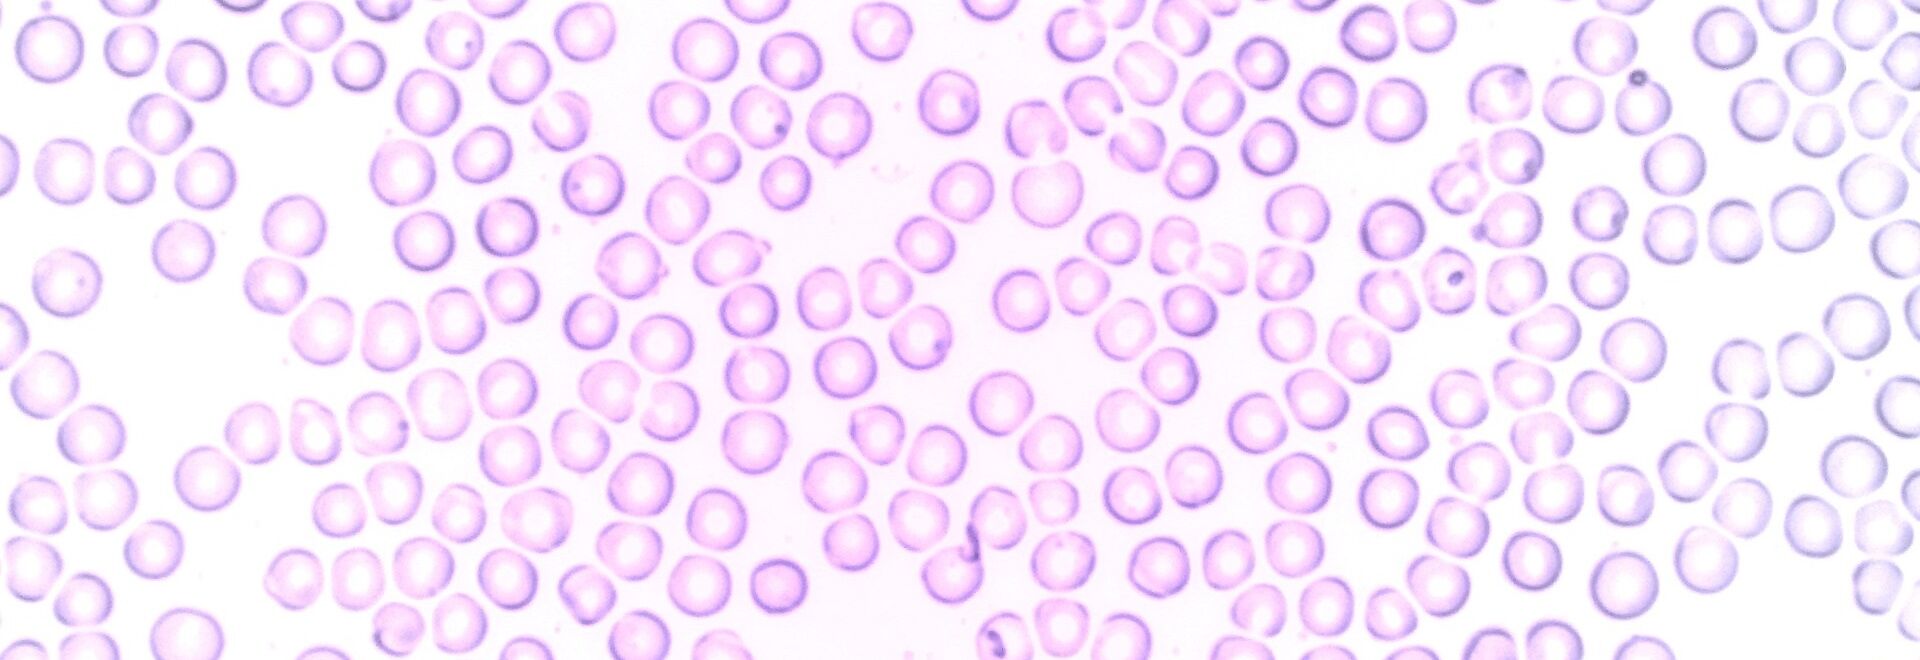

In guten Händen
Wir behandeln gutartige und bösartige Erkrankungen des blutbildenden Systems und des Immunsystems. Dazu gehören:
- Anämie (Blutarmut): Ein Mangel an roten Blutkörperchen oder Hämoglobin, der zu Müdigkeit, Blässe und Schwäche führen kann. Ursachen sind unter anderem Eisenmangel, chronische Erkrankungen oder Vitaminmangel.
- Thrombozytopenie: Eine verminderte Anzahl von Blutplättchen, was das Risiko für Blutungen erhöht.
- Leukopenie: Eine verringerte Anzahl weißer Blutkörperchen, die das Immunsystem schwächen kann.
- Autoimmunerkrankungen.